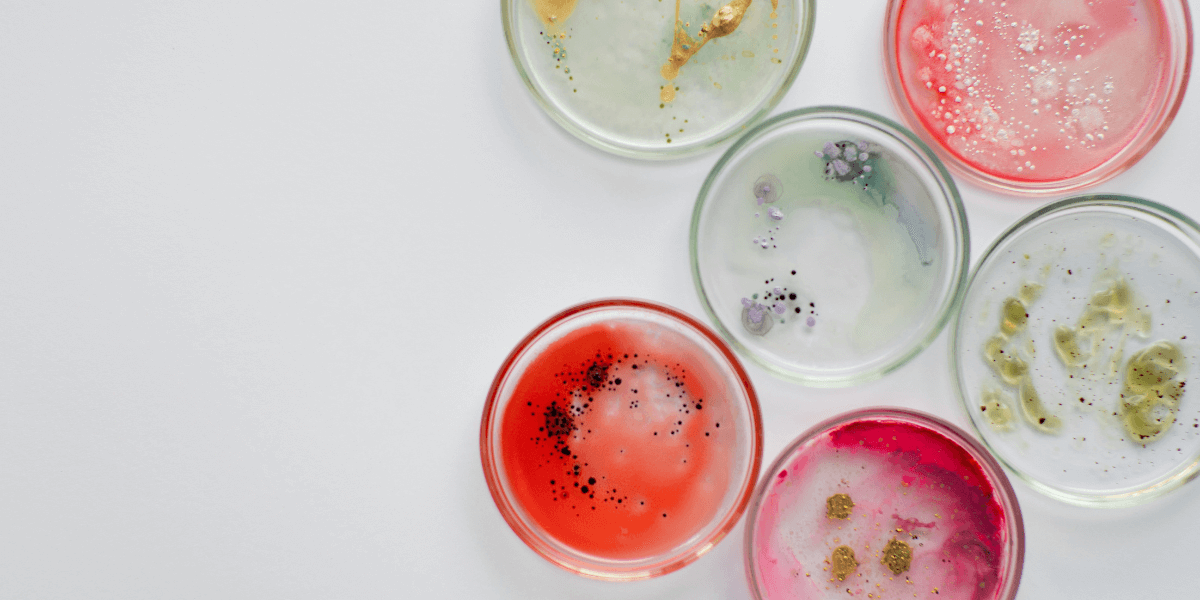

Visualizing the oral microbiome & improved patient care | Jasmine Barth, RDH, CDA, BS

“Seeing is believing, and microscopes are one way we can help our patients to grasp an otherwise obscure idea….When we show a patient the image of their microscopic slide, we can point out the various general categories of bacteria, such as rods, cocci, and spirochetes…In cases of inflammation, white blood cells can also be seen…They can really see how the mouth is connected to the rest of the body,” said Jasmine.
Meet Jasmine
Jasmine Barth, RDH, CDA, BS is a practicing clinical hygienist in San Antonio. I had the privilege of working side by side with her a few years ago, and came to know her as an innovative clinician. Jasmine grew up without exposure to the dental field, and her first dental experience was in the United States Air Force, where she received her first dental care. This led her to become a dental assistant in the USAF, and has stoked her passion for public health, accessibility of care, and education. After her time in the Air Force, she worked as a dental assistant, and decided to go to dental hygiene school. Her favorite part of being a dental hygienist is connecting with her patients. She feels these connections are essential to inspiring health and habit changes in those she serves.
What types of technology excite you for the future of dental hygiene?
Jasmine finds digital radiography, intraoral photography, and cone beam computed tomography (CBCT) technology exciting, but her top pick is the use of a biological microscope. Jasmine said, “We can get down a wormhole when explaining periodontal disease to patients and their eyes start to glaze over. When we can show them the bacteria, we can really get through to them.” She went on to state that it is one thing to tell a patient that the damage to their periodontium is caused by bacteria invisible to the naked eye, but it is something else entirely when we can show them. Seeing is believing, and microscopes are one way we can help our patients to grasp an otherwise obscure idea. Additionally, the microscope is easy to use. A swab is taken of the patient’s mouth, and is smeared onto a microscopic slide. Then the hygienist can view the slide, and many microscopes are equipped to take images that can be added to the patient’s chart for future comparison.
How does the microscope benefit your practice of dental hygiene?
When we show a patient the image of their microscopic slide, we can point out the various general categories of bacteria, such as rods, cocci, and spirochetes. Spirochetes in particular stand out due to their visually distinct characteristics, and the knowledge that they are implicated in periodontitis, especially Treponema denticola [1]. In cases of inflammation, white blood cells can also be seen. Patients get to see for themselves what their bacterial load is like. “They may have heard how the oral microbiome interacts with systemic health. They can really see how the mouth is connected to the rest of the body,” said Jasmine. After non-surgical periodontal therapy, we can take another sample and compare it to the pre-treatment sample.Jasmine expressed one case in which she was able to help a patient change the trajectory of their oral health. “This patient had many active spirochetes when I made the first slide, but he still had relatively shallow pocket depths. Many people in his family had lost their teeth early in life. I completed scaling for active moderate to severe gingival inflammation (D4346), went over oral hygiene instruction, and reappointed for a three-month interval. I was really excited when the slide at his next appointment showed very few spirochetes. It was one of the first cases I thought ‘Wow! This is what we are doing.
What advice would you have for someone who is looking to integrate more progressive ideas or technology into their practice of dental hygiene?
“I think that you can’t do it by yourself. You need to be supported by your whole dental team. Everyone in the practice needs to have a similar mindset and be supportive. If you don’t feel supported, maybe it’s not the place you want to be,” said Jasmine. While there is much more to finding a good practice than technology alone, support goes a long way for a healthy work environment and positive patient outcomes.
- Yousefi, L., Leylabadlo, H. E., Pourlak, T., Eslami, H., Taghizadeh, S., Ganbarov, K., Yousefi, M., Tanomand, A., Yousefi, B., & Kafil, H. S. (2020). Oral spirochetes: Pathogenic mechanisms in periodontal disease. Microbial Pathogenesis, 144, 104193.
https://doi.org/10.1016/j.micpath.2020.104193





